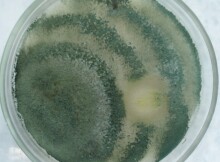

CHANGE OF MICROBIAL FORMATIONS IN ORGANIC POULTRY WASTE MATERIALS DURING NATURAL DEGRADATION PROCESSES
- Authors: Ilyina G.V.1, Ilyin D.Y.1
-
Affiliations:
- Penza State Agrarian University
- Issue: No 1 (2025)
- Pages: 1-10
- Section: Articles
- URL: https://medbiosci.ru/2500-0578/article/view/290021
- DOI: https://doi.org/10.21685/2500-0578-2025-1-3
- ID: 290021
Cite item
Full Text
Abstract
The intensive production of food protein is an integral attribute of modern civilization. Poultry meat production is developing most dynamically all over the world and in Russia, in particular, because this industry is characterized by a short reproduction cycle and quick payback of invested funds. However, the growing rates and volumes of production also entail a progressive increase in waste masses. Litter and poultry litter are transported to landfills or directly to the fields, where over time they undergo natural degradation, accompanied by the emission of gases into the atmosphere and biogens into the soil and groundwater. The ingress of biogens and indigenous microflora of manure into the soil leads to changes in the composition of biocenosis components and the characteristics of their biotopes. The rate and efficiency of degradation depend on the enzymatic potential of the microflora present and the integral effect of endogenous and exogenous factors. Purpose of research: study of dynamics of species composition and environment-forming role of microflora of organic wastes of poultry farming in the processes of their natural destruction and consideration of factors determining the change of formations. In the process of work the following tasks were solved: study of indigenous microflora of poultry litter, study of composition of autochthonous, allochthonous and zymogenic microflora, study of microflora role in formation of substrate transformation vector (reaction and medium temperature), evaluation of microbial formation change regularities. The role of indigenous microflora of manure in the processes of ammonification as a starting stage of degradation of nitrogen-containing waste mass was established. From the process of ammonification starts the step-by-step degradation of manure-litter mixture. The shift of the pH range to the alkaline region caused by the activity of ammonifiers is a factor preventing the proliferation of fungal microflora and degradation of hard-to-degrade polymers. Exposure to high temperatures in the thermal phase of substrate composting is a selection factor sharply modifying the species composition and determining its deep reorganization. The determining role of autochthonous soil microflora at the final stages of organic waste degradation has been established. Species diversity of microorganisms in the masses of organic wastes naturally changes at different stages of degradation. The rates of microbial formations change decrease as the material decomposes, and the dynamic equilibrium of microflora composition is associated with the achievement of a stable balance of biogenic elements, mainly nitrogen and carbon.
About the authors
G. V. Ilyina
Penza State Agrarian University
Author for correspondence.
Email: ilyina.g.v@pgau.ru
Penza, Russia
D. Yu. Ilyin
Penza State Agrarian University
Email: ilyin.d.u@pgau.ru
Penza, Russia
References
- Artem'eva T.N. Patogennaya i uslovno-patogennaya mikroflora kishechnika kur i effektivnost' netraditsionnykh sredstv antibakterial'nogo deystviya: PhD dissertation = Pathogenic and opportunistic microflora of the intestines of chickens and the effectiveness of non-traditional antibacterial agents: PhD thesis. Saint Petersburg, 2004:189. (In Russ.)
- Rodionova N.V. Veterinarno-sanitarnoe i ekologicheskoe obosnovanie sovremennykh sposobov obezzarazhivaniya organicheskikh otkhodov zhivotnovodstva: PhD dissertation = Veterinary-sanitary and ecological substantiation of modern methods of disinfection of organic waste of livestock farming: PhD thesis. Moscow, 2021:99. (In Russ.)
- Fisinin V.I., Trukhachev V.I., Saleeva I.P. et al. Microbiological risks in industrial poultry and livestock farming. Sel'skokhozyaystvennaya biologiya = Agricultural biology. 2018;53(6):1120–1130. (In Russ.)
- Ziganshina E.E. Biokonversiya otkhodov ptitsevodstva anaerobnymi soobshchestvami bakteriy i arkhey: PhD abstract = Bioconversion of poultry waste by anaerobic communities of bacteria and archaea: PhD abstract. Kazan, 2016:28. (In Russ.)
- Il'in D.Yu., Il'ina G.V., Oshkina L.L., Ostapchuk A.V. Microbiota of the intestines of turkeys and litter materials: features and importance in the poultry waste destruction. Niva Povolzh'ya = Niva Povolzhya. 2023;(3). (In Russ.). doi: 10.36461/NP.2023.67.3.015
- Yamaliev T.Sh., Bocharova A.A. Environmental problems of poultry farming. Mir Innovatsiy = The world of innovaitons. 2021;(4):40–43. (In Russ.)
- Crippen T.L., Sheffield C.L, Singh B. et al. Poultry litter and the environment: Microbial profile of litter during successive flock rotations and after spreading on pastureland. Science of The Total Environment. 2021;780:146413.
- Harindintwali J. D., Zhou J., Muhoza B. et al. Integrated eco-strategies towards sustainable carbon and nitrogen cycling in agriculture. Journal of Environmental Management. 2021;293:112856.
- He Y., Zhang Y., Huang X. et al. Deciphering the internal driving mechanism of microbial community for carbon conversion and nitrogen fixation during food waste composting with multifunctional microbial inoculation. Bioresource Technology. 2022;360:127623.
- Iljina G.V., Iljin D.Yu., Zimnyakov V.M., Sashenkova S.A. Influence of organomineral fertilizer based on fermented poultry waste on the physico-chemical parameters of agricultural soils. Scientific Papers. Series A. Agronomy. 2022;65(2):91–96.
- Li F., Ghanizadeh H., Cui G. et al. Microbiome – based agents can optimize composting of agricultural wastes by modifying microbial communities. Bioresource Technology. 2023;374:128765.
- Ravindran B., Karmegam N., Awasthi M.K. et al. Valorization of food waste and poultry manure through co-composting amending saw dust, biochar and mineral salts for value-added compost production. Bioresource Technology. 2022;346:126442.
- Kruglov Yu.V. Soil microbial community: physiological diversity and research methods. Sel'skokhozyaystvennaya biologiya = Agricultural biology. 2016;(1):46–59. (In Russ.)
- Andronov E.E., Ivanova E.A., Pershina E.V. et al. Analysis of soil microbiome indicators in plants associated with soil formation, transformation of organic matter and fine regulation of plant plants. Byul. Pochv. in-ta = Dokuchaev Soil Bulletin. 2015;(80):83–94. (In Russ.)
- Nozhevnikova A.N., Mironov V.V., Bochkova E.A. et al. Composition of the microbial community at different stages of composting, prospects for obtaining compost from municipal organic waste (review). Prikladnaya biokhimiya i mikrobiologiya = Applied biochemistry and microbiology. 2019;55(3):211–221. (In Russ.)
- Belov A.A., Cheptsov V.S., Lysak L.V. Metody identifikatsii pochvennykh mikroorganizmov = Methods of soil microorganisms identification. Moscow, 2020:196. (In Russ.)
- Zvyagintsev D.G. Metody pochvennoy mikrobiologii i biokhimii: ucheb.-metod. posobie = Methods of soil microbiology and biochemistry: study guide. Moscow: MGU, 1991:304. (In Russ.)
- Mannapova R.T. Mikrobiologiya = Microobiology. Moscow, 2019:440. (In Russ.)
- Mirchink T.G. Pochvennaya mikologiya: uchebnik = Soil mycology: textbook. Moscow: Izd-vo MGU, 1988:220. (In Russ.)
- Bergey's Manual of Systematics of Archaea and Bacteria. New York: John Wiley & Sons Inc., 2019. doi: 10.1002/9781118960608 EDN AZDCXJ
Supplementary files